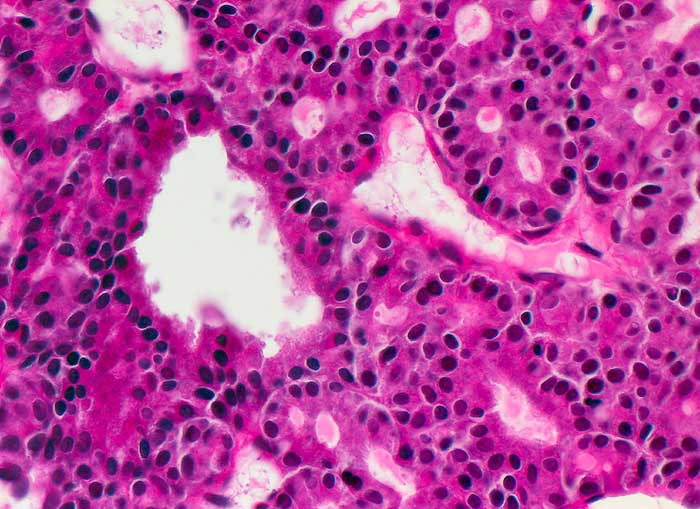

La nésidioblastose du pancréas, terme de racine grecque signifiant tumeur des ilots (de Langerhans), est, avec l'hyperplasie adénomateuse focale, la forme la plus fréquente de l'hyperinsulinisme familial.
Lorsque cette maladie est secondaire à une mutation du gène KCNJ11, ce syndrome fait partie du groupe des canalopathies.
Sources
- (en) Benjamin Glaser, Familial Hyperinsulinism In GeneTests: Medical Genetics Information Resource (database online). Copyright, University of Washington, Seattle. 1993-2005 [1]
- Portail de la médecine